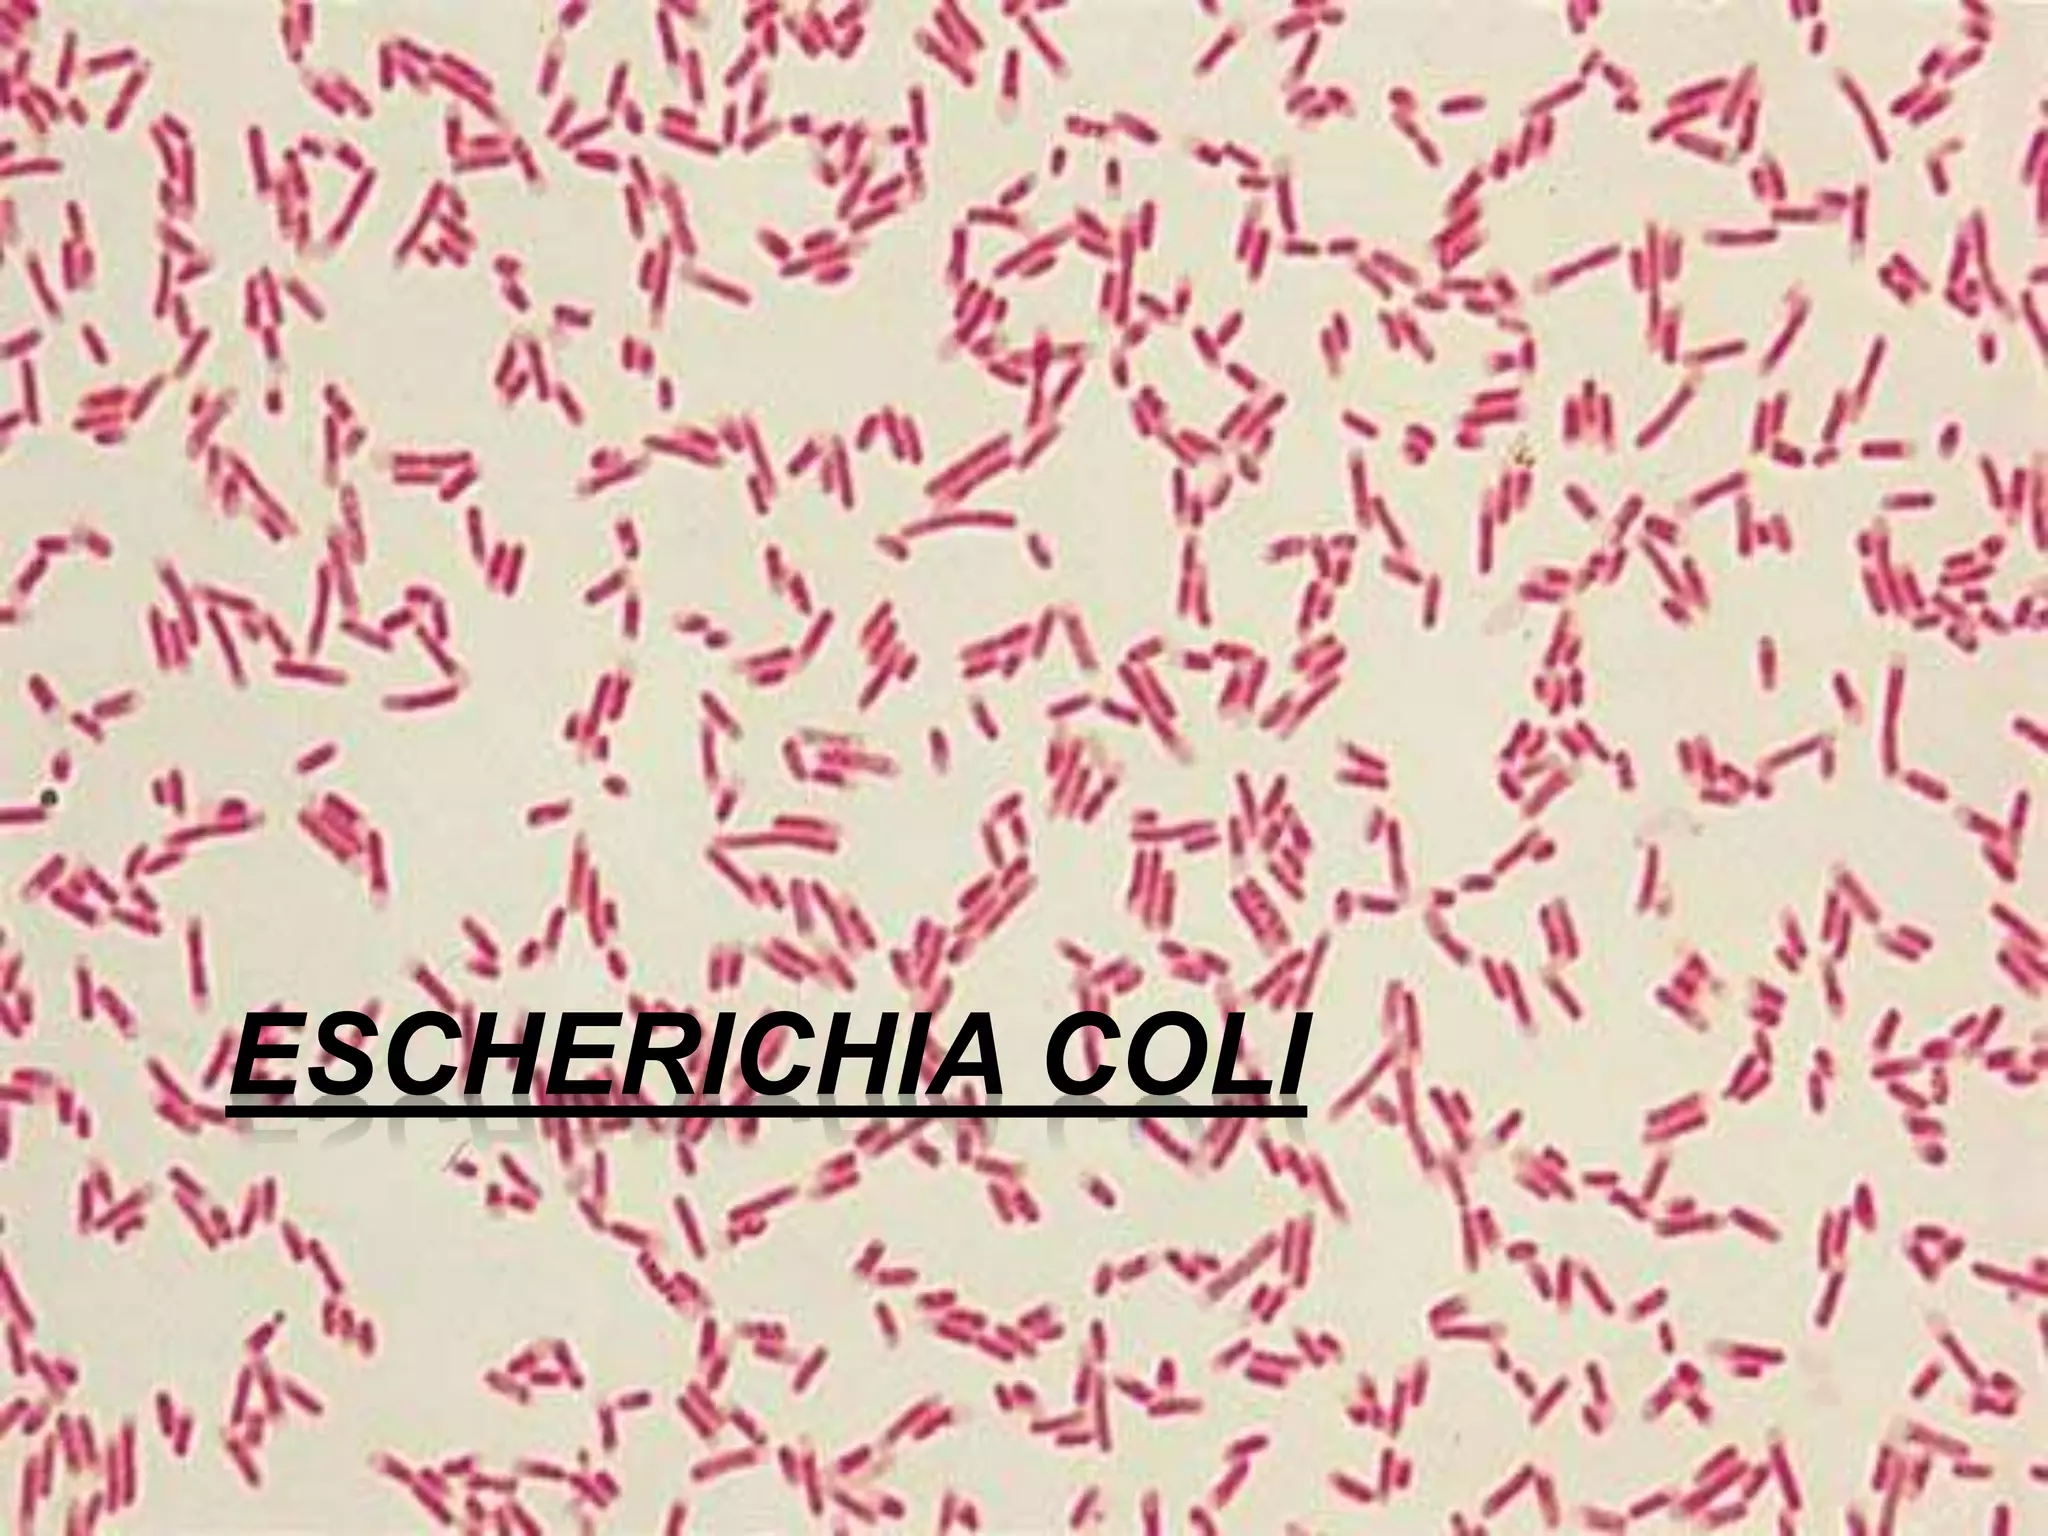
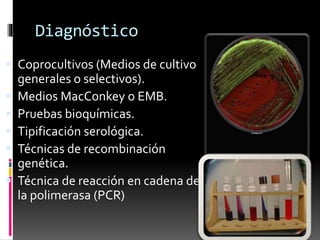
Diagnóstico 
 Coprocultivos (Medios de cultivo 
generales o selectivos). 
 Medios MacConkey o EMB. 
 Pruebas bioquímicas. 
 Tipificación serológica. 
 Técnicas de recombinación 
genética. 
 Técnica de reacción en cadena de 
la polimerasa (PCR)

Escherichia coli es una bacteria Gram negativa que puede causar diversas enfermedades como diarrea. Existen cinco grupos principales de E. coli basados en sus características patogénicas: enteropatógena, enteroinvasiva, enterohemorrágica, enteroagregativa y enterotoxigénica. Cada grupo se caracteriza por su epidemiología, cuadro clínico y síntomas como diarrea y fiebre. El diagnóstico incluye pruebas de laboratorio como coprocultivos, bioquímica y té